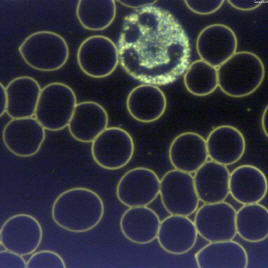

Dunkelfeld-Vitalblut-Analyse
Unser Blut - Spiegelbild unserer Gesundheit
Kennen Sie dieses Problem auch?
Sie gehen zum Arzt, weil Sie sich schon seit einiger Zeit müde, unwohl oder krank fühlen und lassen Ihr Blut untersuchen. Einige Tage später berichtet Ihnen Ihr Arzt: „Alles ok! – Ihre Blutwerte sind bestens – Ihnen fehlt nichts!“ Trotzdem fühlen sich weiter müde und krank.
Wie kann das sein?
Das ärztliche Blutbild wird erst einige Zeit nach der Entnahme im Labor untersucht. Bei dieser Untersuchung werden quantitative (mengenmässige) Blutbestandteile (rote und weisse Blutkörperchen, Blutplättchen) und Blutinhalte (Enzyme, Hormone, Zucker, Fette) bestimmt und mit sogenannten Normwerten verglichen.
In der Regel werden dabei Blutkörperchen angefärbt und gezählt. Dabei sterben diese ab.
Die Menge dieser Blutbestandteile sagt aber nichts oder nur wenig über die Qualität der roten und weissen Blutkörperchen aus.
Eine Lösung bietet die Dunkelfelddiagnostik nach Prof. Dr. Günther Enderlein an.
Dunkelfelddiagnostik, der andere Blick ins Blut
Bei der Dunkelfelddiagnostik genügt ein Tropfen Blut, der aus der Fingerkuppe entnommen wird, um aktuelle Rückschlüsse auf den Gesundheitszustand zu erhalten.
Die Lebendprobe wird direkt bei 1200-facher Vergrösserung unter einem Dunkelfeldmikroskop untersucht. Dabei wird das Objekt von der Seite her angestrahlt, und der Hintergrund bleibt dunkel. So können kleinste Zellen und Strukturen wahrgenommen und bestimmt werden. Der Bluttropfen wird so lange beobachtet, bis er zerfallen ist. Belastungen, vor allem von Mikroben, werden oft erst nach mehreren Stunden sichtbar.
Übersäuerung, Stress, falsche Ernährung, Schwermetalle, Medikamente, Mikroorganismen oder auch Umweltgifte – ergeben unter dem Mikroskop typische Blutbilder.
Ursache
Das körpereigene Milieu ist heute oft durch falsche Ernährung, Wassermangel und Stress gestört. Da unser Körper viele Möglichkeiten besitzt, um diesen Nährboden zu regulieren, geht das eine ganze Weile gut und wir fühlen uns gesund.
Irgendwann wird dann bemerkt, dass etwas nicht mehr stimmt. Es treten erste, schleichende „Unpässlichkeiten“ und Symptome auf, wie zum Beispiel:
- Kopf-, Muskel- und Gliederschmerzen
- Müdigkeit
- Schlaflosigkeit
- Durchblutungsstörungen
- Allergien
- Bluthochdruck
- Verdauungs- und Gewichtsprobleme
- verminderte Leistungsfähigkeit oder
- Immunschwäche, etc.
Im Dunkelfeldmikroskop kann man diese Milieuveränderungen schon sehr früh und gut erkennen. Es können sich auch weitere Erkenntnisse über die Vitalität des Blutes und eventuelle Krankheiten ergeben.
Nur mit dem Erkennen der Störungen ist es natürlich noch nicht getan!
Wie bieten auch Lösungen an:
Zur Beseitigung und Behandlung der Dunkelfeldphänomene steht Ihnen ein breites Spektrum an nebenwirkungsfreien, isopathischen Medikamenten, Kräutertinkturen und therapeutischen Vitalstoffen zur Verfügung.
Oft kann auch ein krankhafter Prozess mit einer typgerechten Lebensmittelumstellung positiv beeinflusst werden.